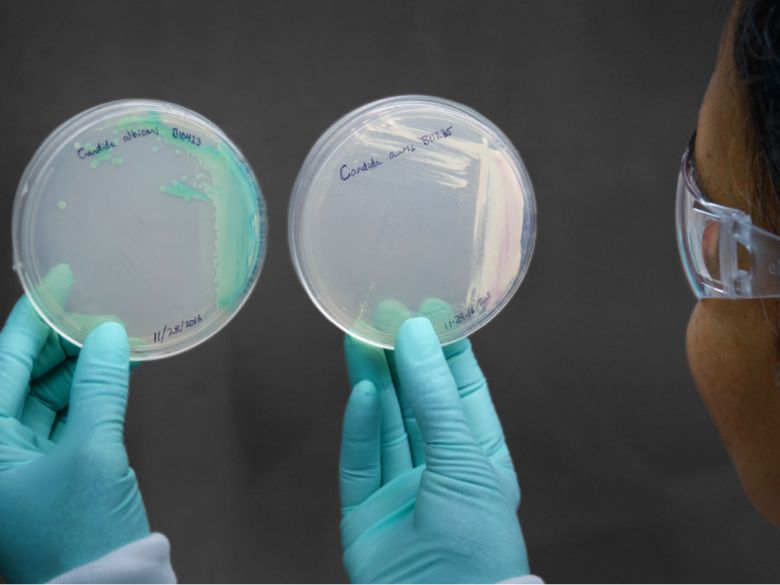
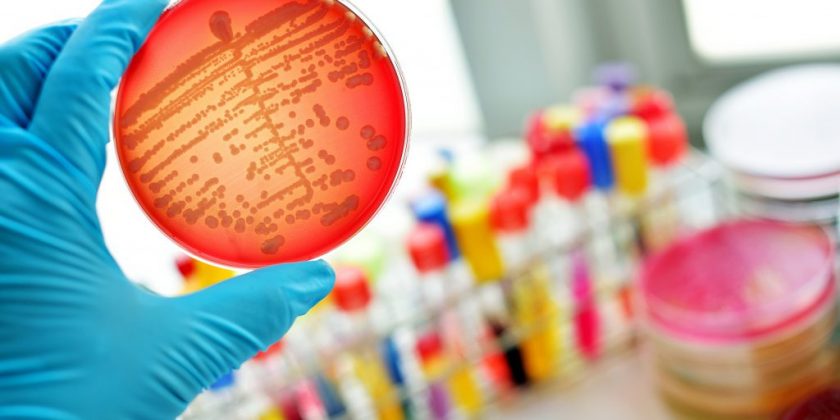

The Science Behind Shedding Pounds: Why Summers Are the Best Time to Lose Weight
- Sunday | 14th April, 2024
"Marching Towards Health: Why March is the Best Time to Start Your Weight Loss Plan
- Thursday | 14th March, 2024
Love and Wellness: Nurturing Heartfelt Health in Celebration of Valentine`s Day
- Thursday | 8th February, 2024
Hydration Health: Finding the Right Balance - How Much Water is Beneficial for Your Well-being?
- Thursday | 25th May, 2023

.png)








